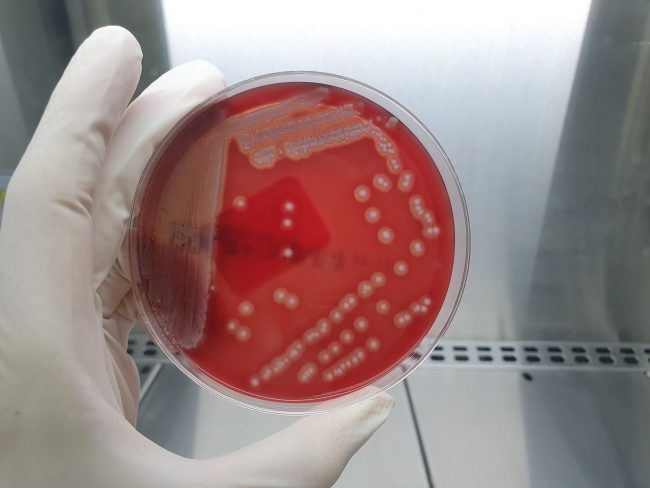
Escherichia coli beta hemolítico 2

Escherichia coli beta hemolítico
Escherichia coli beta hemolítico es una bacteria patógena que afecta principalmente a lechones neonatos y destetados, provocando cuadros graves de diarrea y septicemia. Su capacidad de hemólisis, es decir, la destrucción de glóbulos rojos, le confiere una mayor virulencia y agrava el impacto de la infección. Los signos clínicos más comunes incluyen diarrea profusa de…